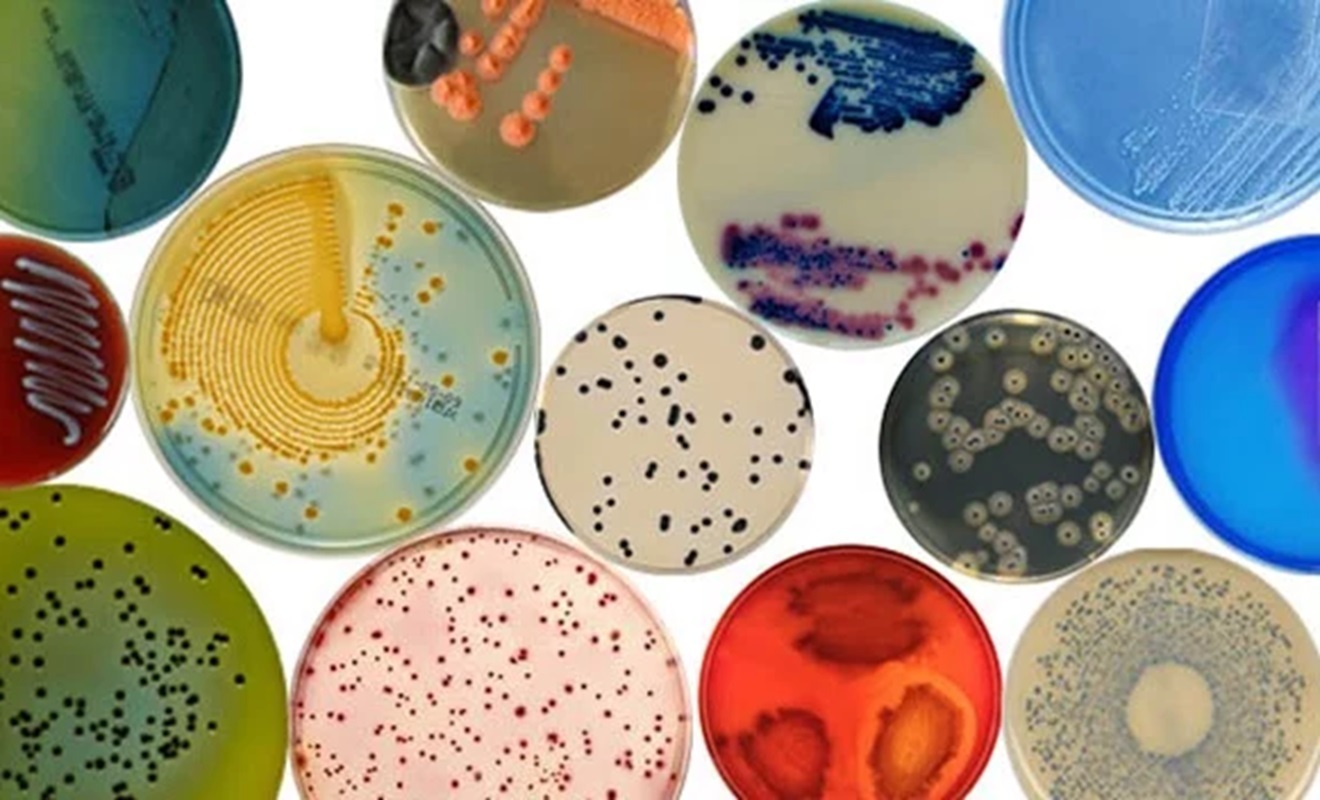

лодным средам относится
К голодным средам относится 109 фото
Посудомоечной машине стоит вода в фильтре
Писает где стоишь
Капитальный ремонт продаже квартиры
Iptvplay
Как расшифровывается лп
Дверной замок тула
Как отгрузить fbs озон
Шпон в новосибирске
Короткометражка седой
Какие можно сделать рулет из лаваша